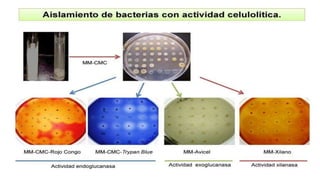
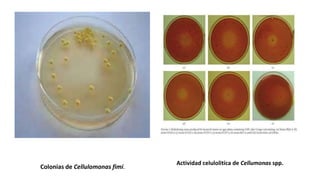
Colonias de Cellulomonas fimi.
Actividad celulolitíca de Cellumonas spp.
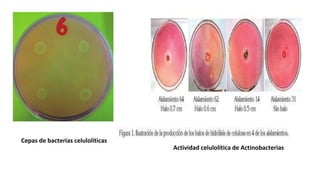
Actividad celulolítica de Actinobacterias
Cepas de bacterias celulolíticas
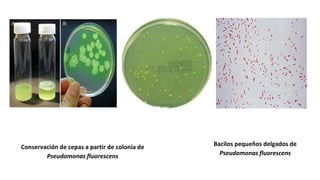
Conservación de cepas a partir de colonia de
Pseudomonas fluorescens
Bacilos pequeños delgados de
Pseudomonas fluorescens
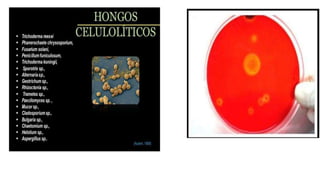
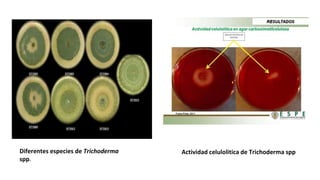
Diferentes especies de Trichoderma
spp.
Actividad celulolitica de Trichoderma spp
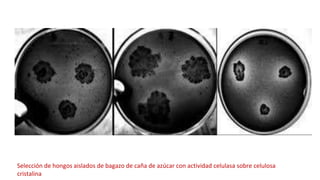
Selección de hongos aislados de bagazo de caña de azúcar con actividad celulasa sobre celulosa
cristalina

Este documento describe los procedimientos para el aislamiento y selección de microorganismos celulolíticos a partir de muestras de suelo y desechos agroindustriales. Se utilizan medios de cultivo selectivos para identificar bacterias y hongos con la capacidad de degradar la celulosa. Entre los microorganismos aislados se encuentran especies de Cellulomonas, Cytophaga, Actinobacterias, Pseudomonas, Trichoderma y hongos aislados de bagazo de caña de azúcar. Finalmente, el